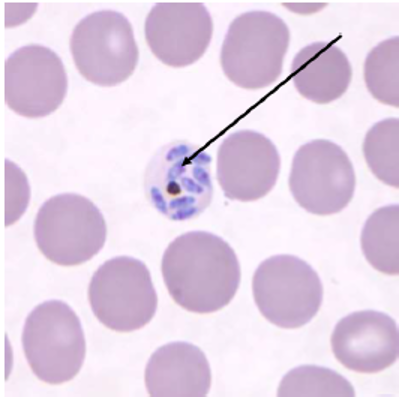
knowt flashcard image
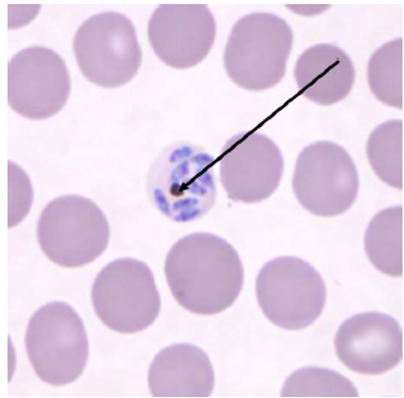
knowt flashcard image
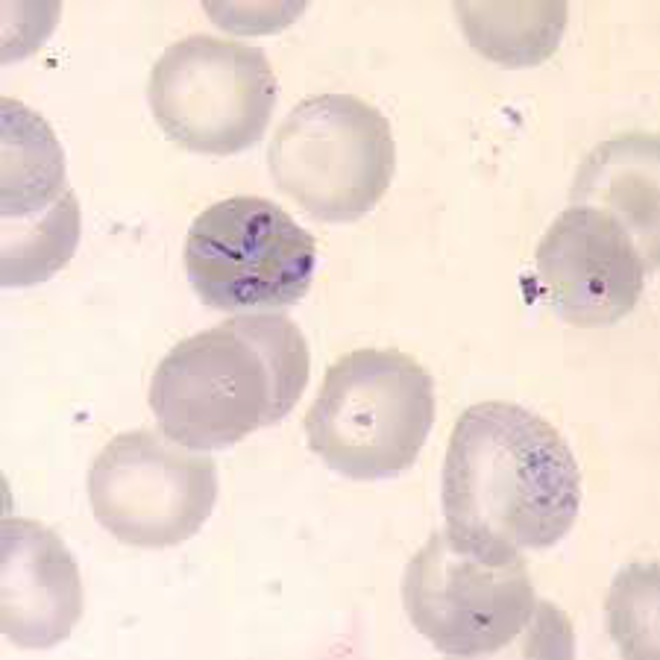
knowt flashcard image
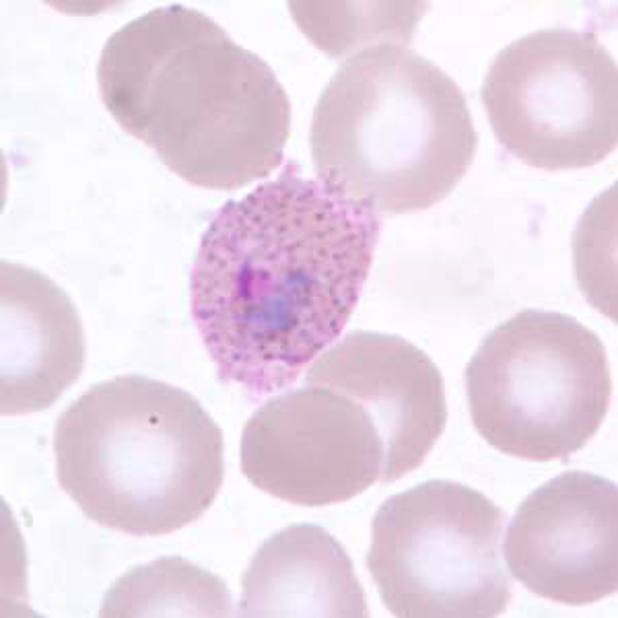
knowt flashcard image
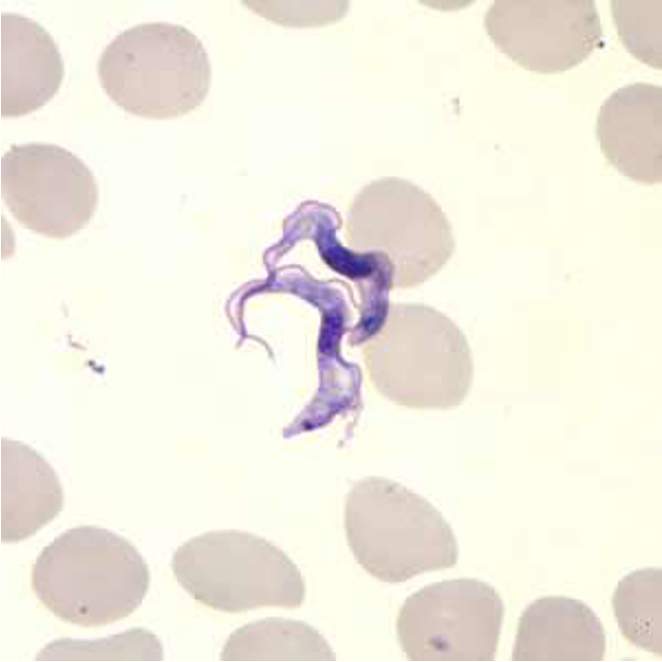
knowt flashcard image
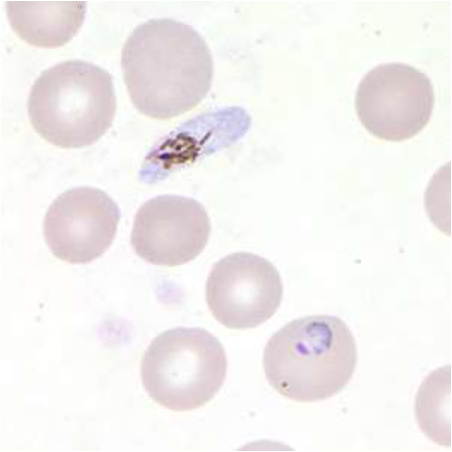
knowt flashcard image
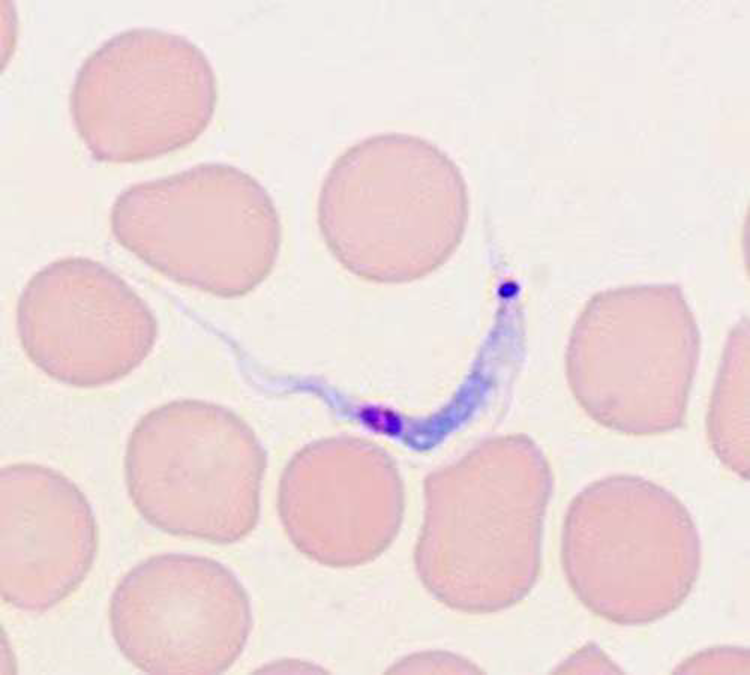
knowt flashcard image
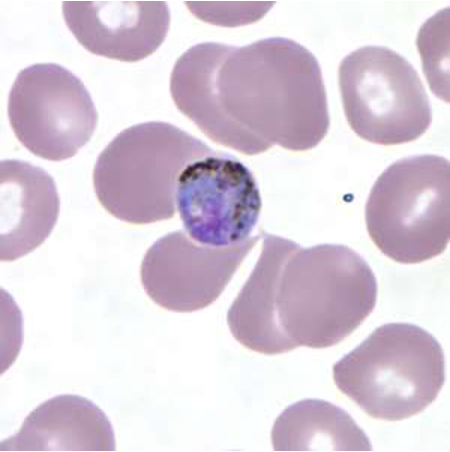
knowt flashcard image
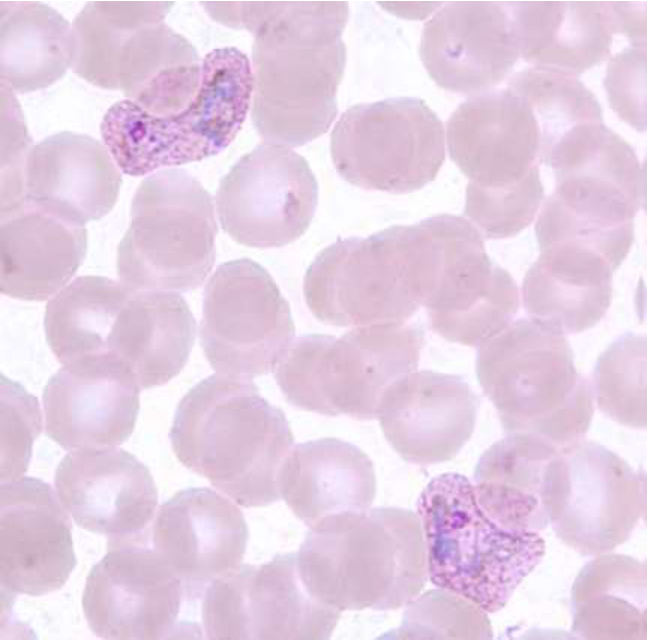
knowt flashcard image
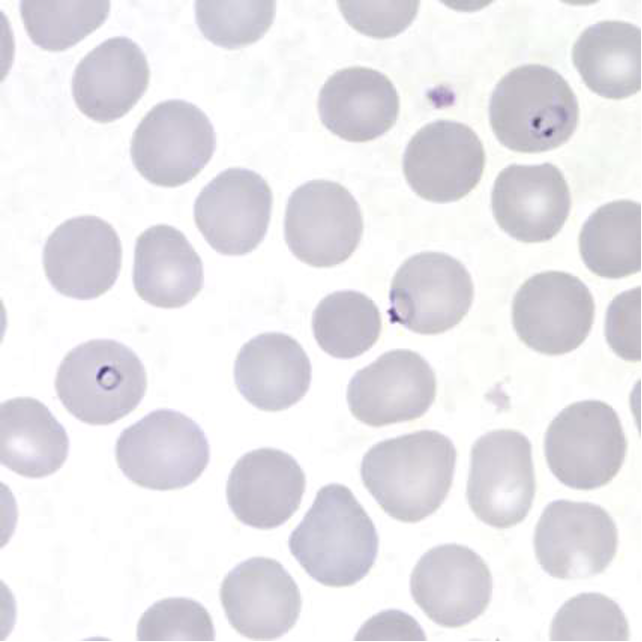
knowt flashcard image
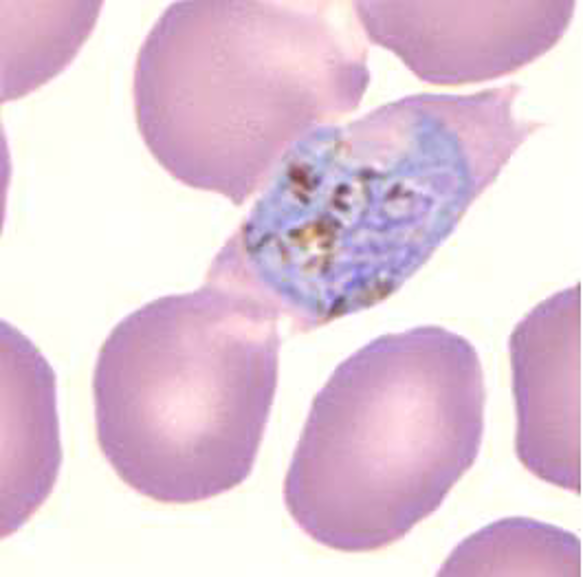
knowt flashcard image
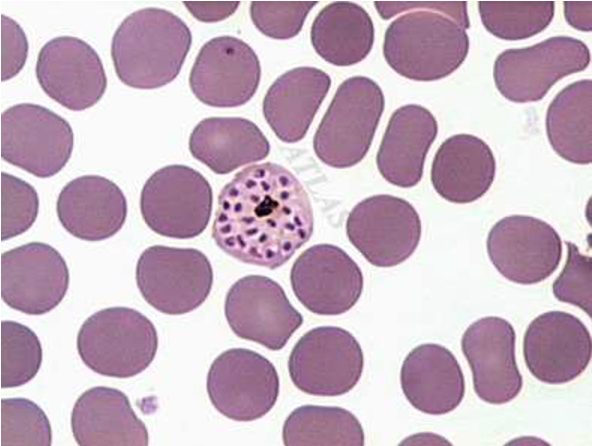
knowt flashcard image

1/73
Looks like no tags are added yet.
Name | Mastery | Learn | Test | Matching | Spaced | Call with Kai |
|---|
No analytics yet
Send a link to your students to track their progress
chromatoid body (from: entamoeba histolytica cyst)

trypanosoma cruzi trypimastigote

Babesia species

endolimax nana trophozoite

cystoisospora belli oocyst

entamoeba polecki cyst

plasmodium vivax schizont

giardia intestinalis cyst

glycogen vacuole (from: entamoeba coli cyst)

Giardia intestinalis- trophozoite

median body (from: Giardia intestinalis cyst)

plasmodium malariae trophozoite

axostyle (from: trichomonas vaginalis trophozoite)

chilomastix mesneli trophozoite

exflagellation microgametocyte plasmodium

merozoites (from: Plasmodium knowlesi into a mature schizont)
nuclei (from: Plasmodium knowlesi in a mature schizont)
pneumocystis jirovecii
Bronchial alveolar lavage, Giemsa stain

entamoeba coli cyst

entamoeba hartmanni trophozoite

acanthamoeba species cyst
Cornea Scraping

sarcocystis species bradyzoites
Muscle Biopsy

trypanosoma cruzi trypomastigote

babesia species trophozoite
undulating membrane (from: trichomonas hominis trophozoite)

plasmodium ovale trophozoite
schuffner’s dots (from: plasmodium vivax trophozoite??)

trypanosoma brucei trypomastigote
sarcocystis species oocyst

toxoplasma gondii bradyzoites ??
Brain Tissue

entamoeba hartmanni cyst
8 µm

balantidium coli trophozoite
55 µm

blastocystis enterocola trophozoite

entamoeba histolytica trophozoite ???
16 µm

entamoeba histolytica trophozoite

cryptosporidium species oocyst ??

cryptosporidium species oocyst
4 µm Modified Acid Fast Stain

plasmodium falciparum microgametocyte
balantidium coli cyst
65 µm

blastocystis enterocola

macronucleus (from: Balantidium coli trophozoite)

micronucleus (from: balantidium coli trophozoite)

trypanosoma cruzi amastigote
Heart Tissue

endolimax nana cyst
9 µm

microsporidium species
1 µm Chromotrope Stain

Cystoisospora
Calcofluor White Stain

cyclospora cayetanensis oocyst
10 µm Modified acid-fast stain

toxoplasma gondii tachyzoite
Bone Marrow

trypanosoma rangeli trypimastigote ??
Naegleria fowleri -trophozoite
CSF
Wright Stain

Plasmodium malariae- gametocyte
cystoisospora species oocyst ??
Modified acid-fast stain

sarcocystis species bradyzoites
Muscle Biopsy

cystoisospora belli oocyst
sporocyst?

merozoites or schizont (from: toxoplasma gondii)

cyst wall (from: cystoisospora belli oocyst)

plasmodium vivax trophozoite
leishmania donovani amastigote

spiral groove (from: Chilomastix mesneli trophozoite)

plasmodium falciparum ring trophozoite
iodamoeba butschlii cyst

pneumocystis jirovecii

cyclospora cayetanensis oocyst

plasmodium falciparum gametocyte

cryptosporidium species oocyst

plasmodium ovale trophozoite
trichomonas tenax trophozoite

toxoplasma gondii tachyzoites ??

entamoeba histolytica cyst

plasmodium vivax schizont
iodamoeba butschlii trophozoite

leishmania tropica amastigote
Skin scraping
Wright stain

chilomastix mesneli cyst

entamoeba gingivalis trophozoite
Source IUD
